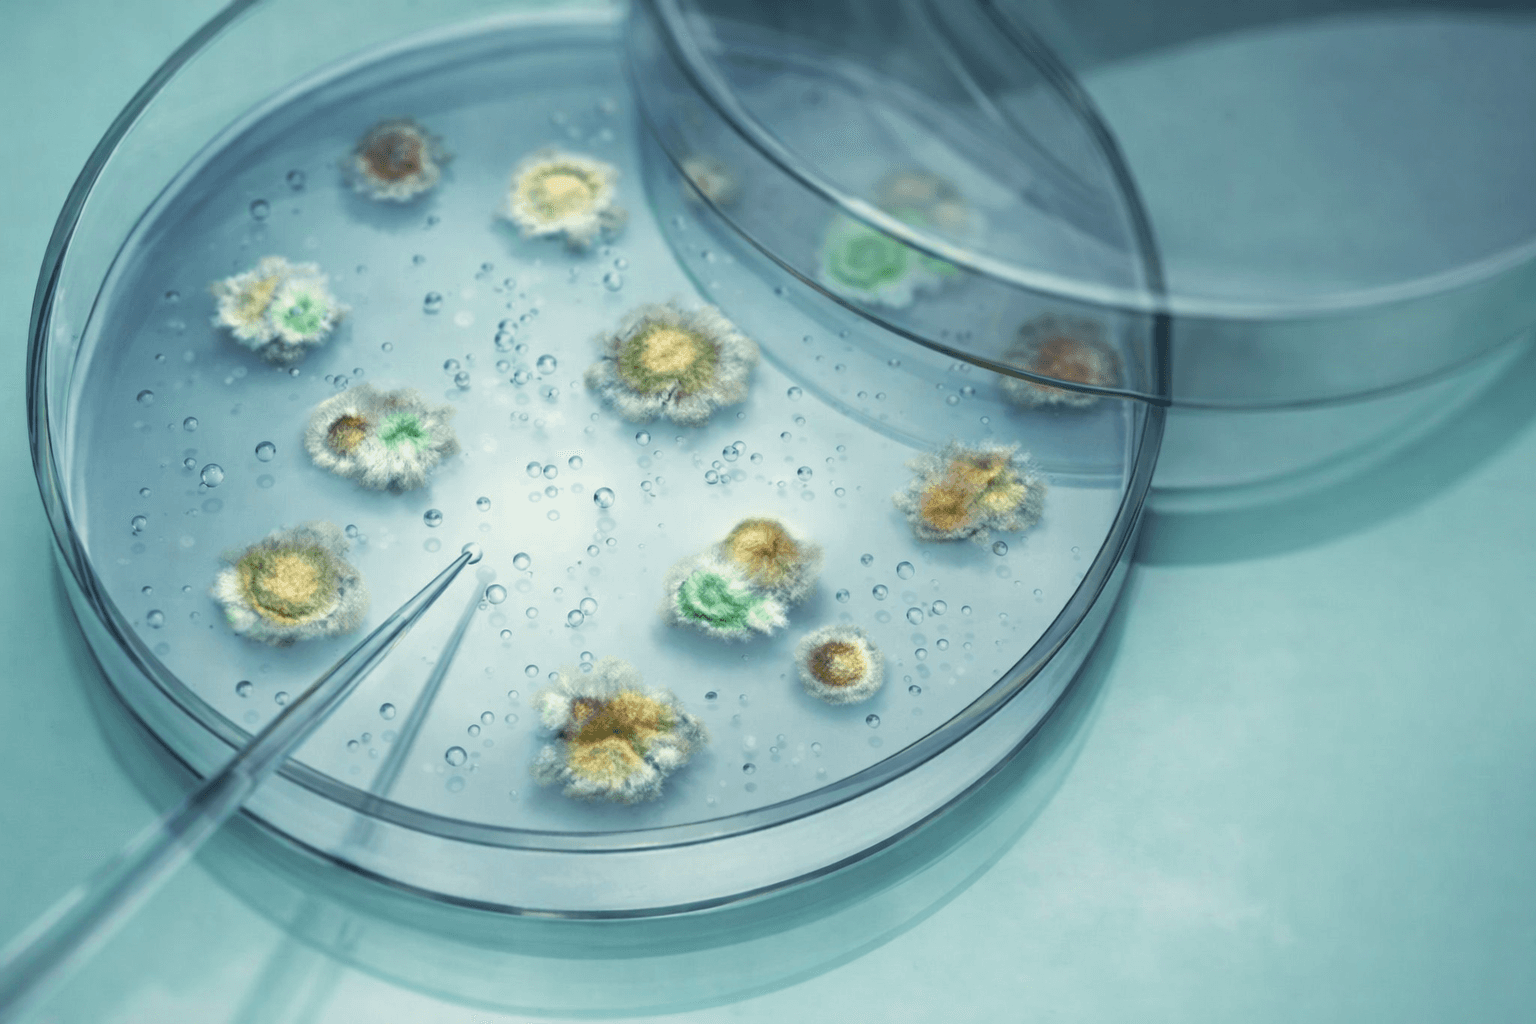
three clear beakers placed on tabletop

Non-human genomics is diverse by nature: high variability, complex populations, and fast-evolving genomes. Pangenomic analysis becomes practical at scale, so you can compare samples fairly, detect meaningful variation in challenging regions, and move from data to action quickly.
The benefits
Faster insights, higher-quality calls, and scalable analysis. Powered by pangenomics.
Move beyond a single reference
Reduce reference-driven blind spots when working with diverse populations, breeds, cultivars, and fast-evolving genomes.
Pangenomic-powered population genomics
Go from “data” to “decision” faster by correlating genotype and phenotype across cohorts, powering strain/variety selection and trait discovery.
Speed to actionable results
Not just faster compute: fewer cycles to reach a confident choice (what to select, what to scale, what to monitor).
Scales across organisms and workflows
Run consistent analysis from pilots to production, across short- and long-read data, without locking into a single vendor or deployment model.